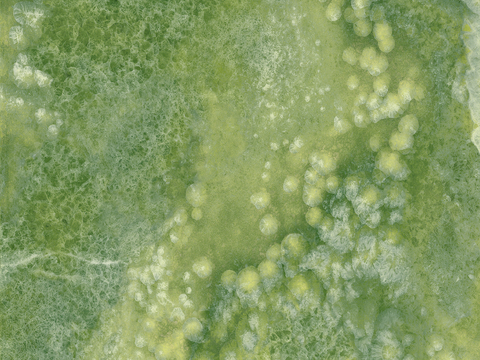
马可波罗 大理石 瓷砖 金玉满堂 绿色岩板

模型详情
马可波罗大理石瓷砖岩板四季粉秋
ID:5326411马可波罗大理石瓷砖岩板四季粉秋 ID-5326411
所需欧币:
4
发布时间:
2026-01-20
下载请使用电脑登录欧模网,建议先收藏
收藏
分享
为您推荐

马可波罗大理石瓷砖岩板四季粉秋

马可波罗大理石瓷砖岩板四季粉夏

马可波罗大理石瓷砖岩板四季粉春

马可波罗瓷砖 冰晶琥珀深色 粉水晶岩板 大理石瓷砖

马可波罗瓷砖 冰晶琥珀浅色 粉水晶岩板 大理石瓷砖

现代法式四季粉大理石

马可波罗 大理石 瓷砖 冰晶琥珀 粉水晶岩板 玉石透光石

马可波罗 大理石 瓷砖 冰晶琥珀 粉水晶岩板 玉石透光石

马可波罗 大理石 瓷砖 冰晶琥珀 粉水晶岩板 玉石透光石

马可波罗 大理石 瓷砖 冰晶琥珀 粉水晶岩板 玉石透光石

马可波罗 大理石 瓷砖 冰晶琥珀 粉水晶岩板 玉石透光石

马可波罗 大理石 瓷砖 冰晶琥珀 粉水晶岩板 玉石透光石

法式轻奢四季粉大理石

四季粉大理石奢石

马可波罗瓷砖 大理石瓷砖 白玉岩板 透光石

马可波罗 大理石 瓷砖 金玉满堂 米色岩板

马可波罗 大理石 瓷砖 金玉满堂 绿色岩板
马可波罗 大理石 瓷砖 金玉满堂 绿色岩板

马可波罗 大理石 瓷砖 金玉满堂 绿色岩板

马可波罗 大理石 瓷砖 金玉满堂 米色岩板
